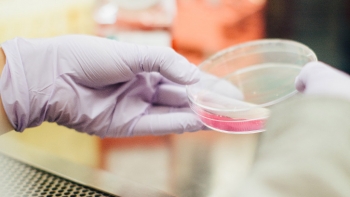

U FOKUSU: Covid19
Vakcinacija u Leliću i Leskovicama, revakcinacija u Divcima
U subotu 19. juna Dom zdravlja Valjevo organizuje vakcinaciju protiv virusa korona u Leliću i Leskovicama. Od 8 do 11 časova Sinofarm vakcinu će jedna ekipa davati u ambulanti u...
U FOKUSU: Privreda
UZ PODRŠKU AMERIČKE AMBASADE GRADI SE JOŠ JEDAN VRTIĆ U VALJEVU
Zahvaljujući Programu humanitarne podrške Evropske komande Sjedinjenih Američkih Država, koji je uložio milion dolara, u Valjevu će biti izgrađen...
U VALJEVU SVEČANO OTVOREN HANSGROE
Zajedničkim presecanjem crvene trake od strane generalnog direktora kompanije Hansgroe, Hansa Jirgena Kalmbaha, ambasadorke Savezne republike...
MINISTARKA VUJOVIĆ U OSEČINI NAJAVILA I POČETAK IZGRADNJE DEPONIJE KALENIĆ U JULU OVE GODINE
Ministarka za zaštitu životne sredine Republike Srbije Irena Vujović posetila je opštinu Osečina, najavivši otvaranje još jedne toplane koja će...
SAJAM OTVORENIH VRATA DUALNOG OBRAZOVANJA
U Centru za kulturu u Valjevu je održan prvi Sajam otvorenih vrata dualnog obrazovanja u organizaciji PKS, RPK Valjevo, Školske uprave i NSZ....
REKONSTRUKCIJA I IZGRADNJA VODOVODNE MREŽE
Zbog povoljnih vremenskih prilika, operativa valjevskog vodovoda obavljala je radove na rekonstrukciji i izgradnji vodovodne mreže do poslednjeg...
“EUROPROM” stigao i u Kličevac u Valjevu
U Ulici Jakova Nenadovića u naselju Kličevac u Valjevu, krajem aprila otvoren je još jedan maloprodajni objekat kompanije “Europrom”.
U FOKUSU: Obrazovanje i kultura
UZ PODRŠKU AMERIČKE AMBASADE GRADI SE JOŠ JEDAN VRTIĆ U VALJEVU
Zahvaljujući Programu humanitarne podrške Evropske komande Sjedinjenih Američkih Država, koji je uložio milion dolara, u Valjevu će biti izgrađen...
UČENICI U SREDNJE ŠKOLE RASPOREĐENI U PRVOM UPISNOM KRUGU
Prvi upisni krug za srednje škole završen je 3. jula, dok je 5. jul bio rezervisan za drugi upisni krug. Svi učenici u Kolubarskom i Mačvanskom...